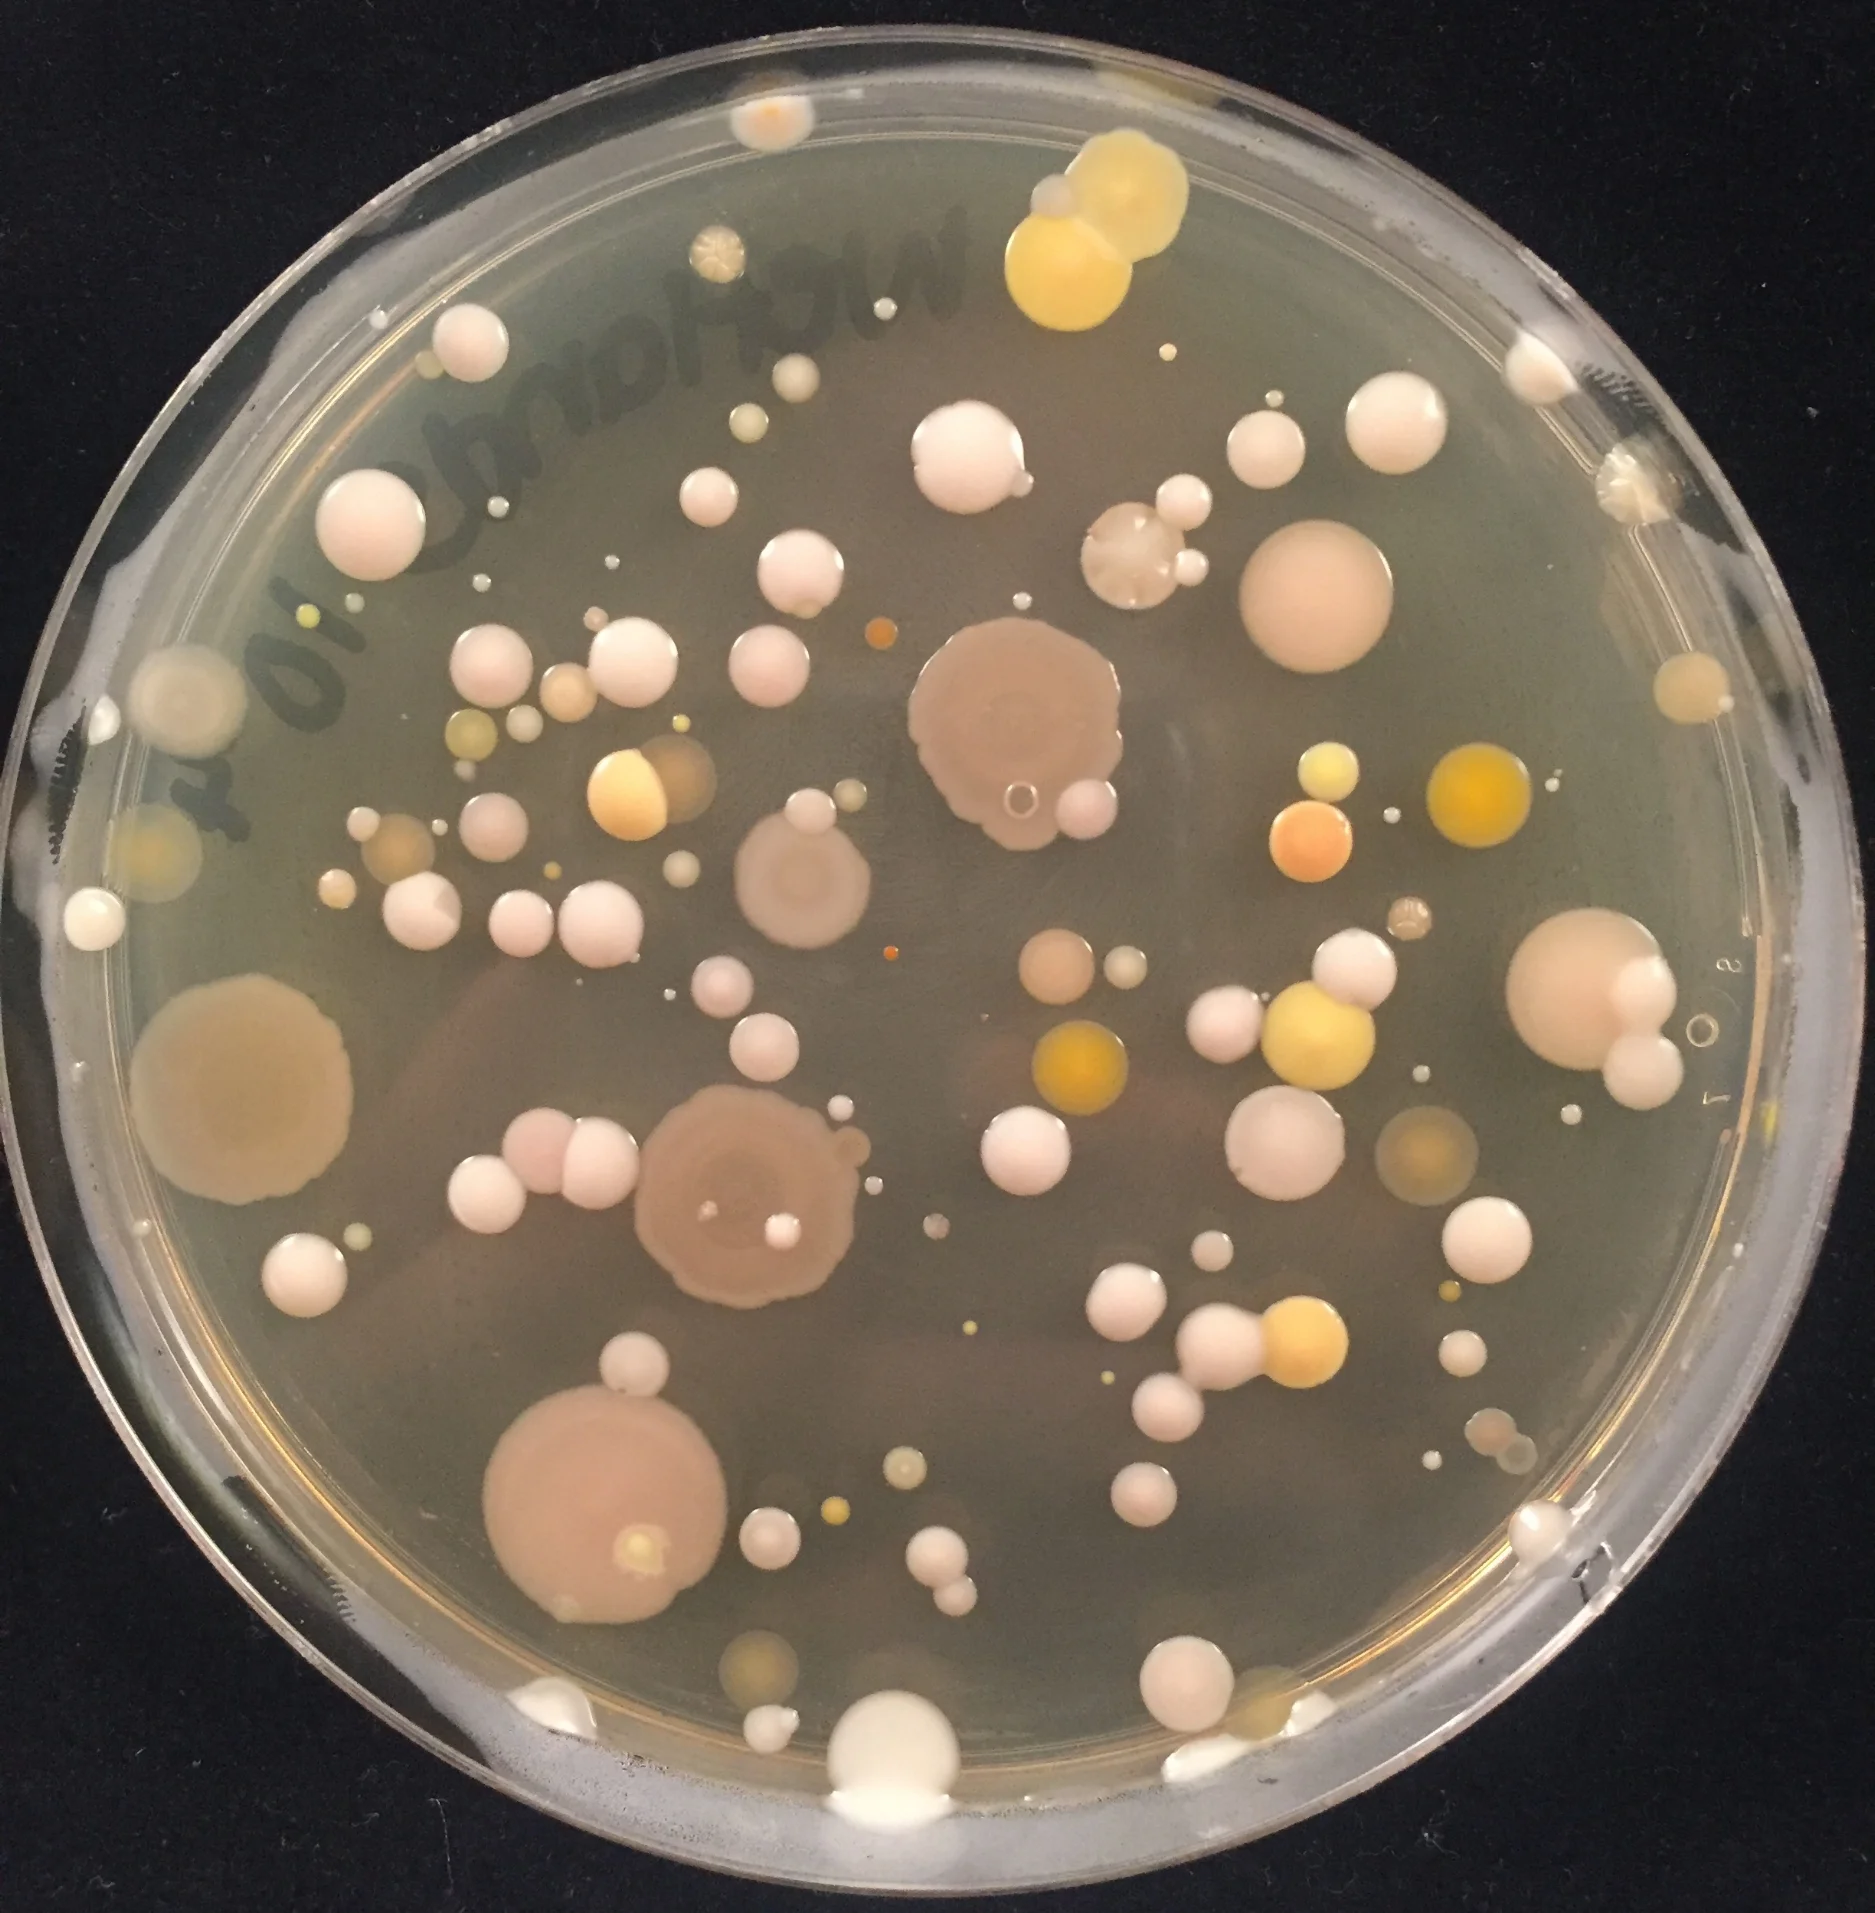
IMG_6219.jpeg
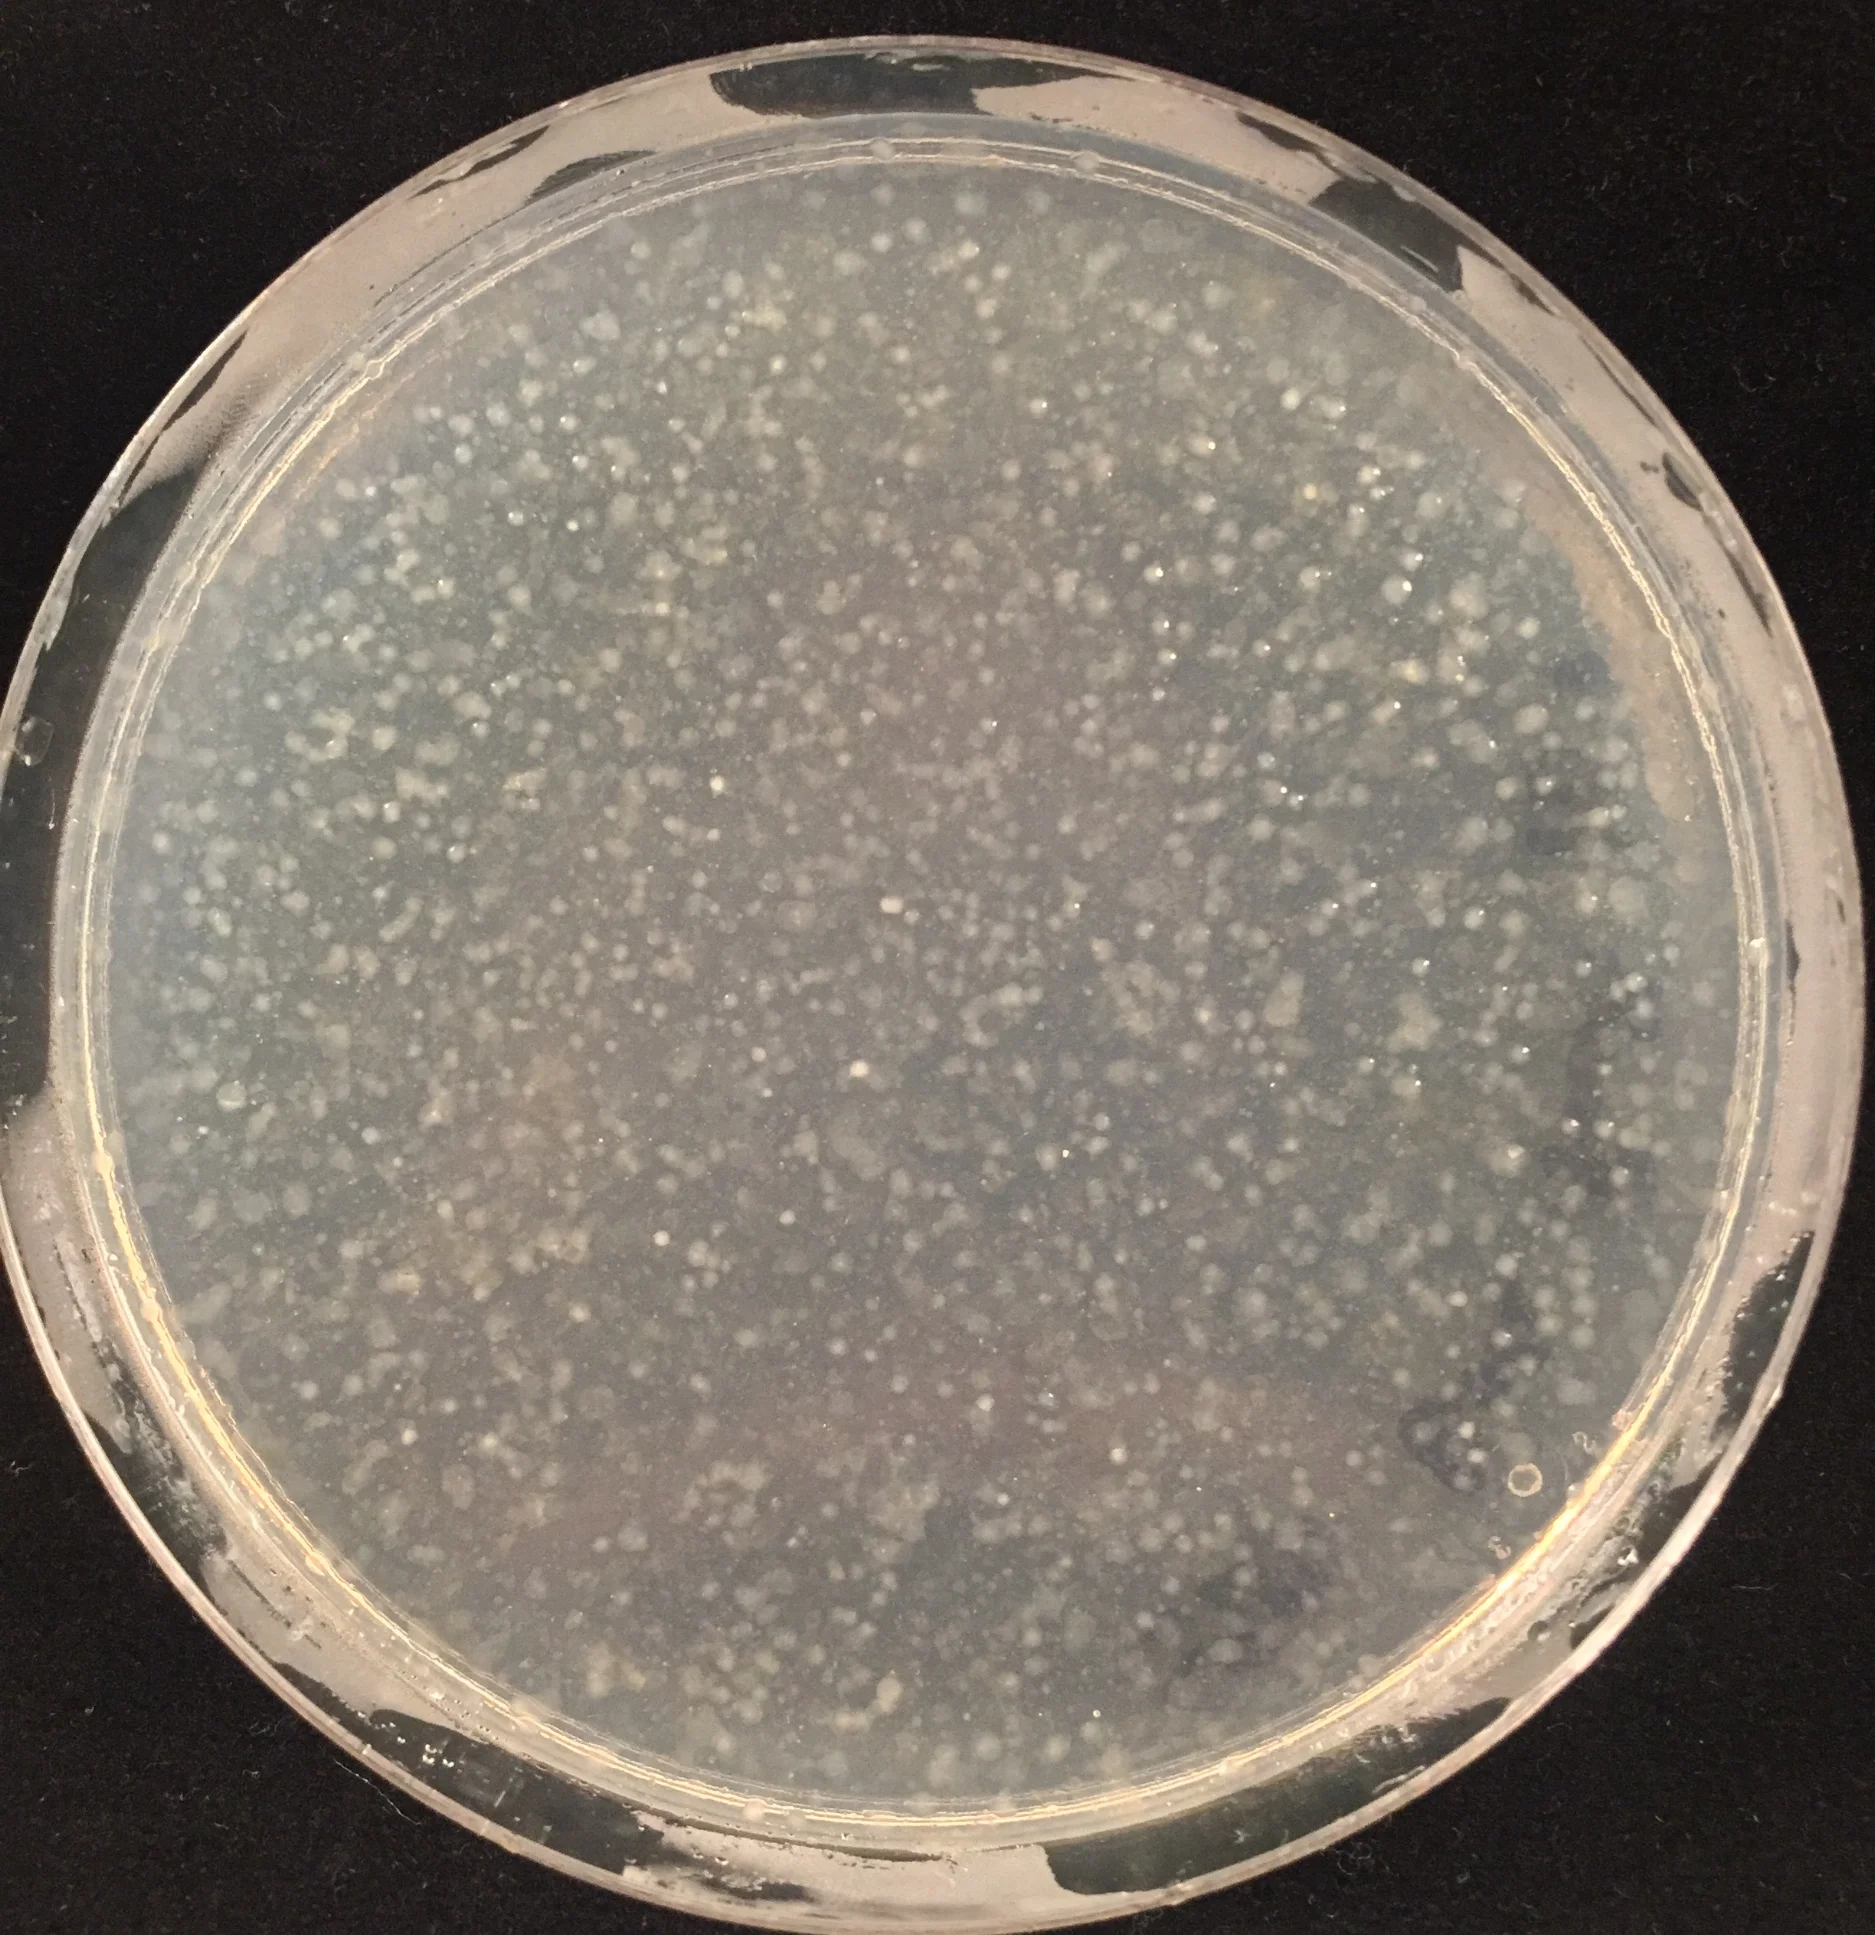
IMG_6237.jpeg

Welcome to
THE WRIGHT LAB
McMaster University, Hamilton, Ontario
&
Michael G. DeGroote Institute for Infectious Disease Research
&
David Braley Centre for Antibiotic Discovery
McMaster University, Hamilton, Ontario
&
Michael G. DeGroote Institute for Infectious Disease Research
&
David Braley Centre for Antibiotic Discovery